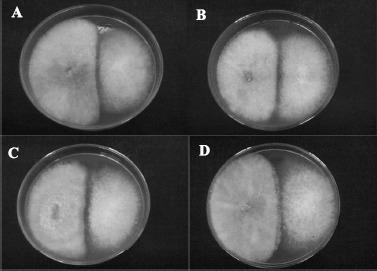
https://cdn.ncbi.nlm.nih.gov/pmc/blobs/9bed/3768515/3a944eb19afd/bjm-40-73-g001.jpg

从紫草(Symphytum officinale L.)中选择内生真菌,用于体外生物防治植物病原菌核盘菌(Sclerotinia sclerotiorum)。
Selection of endophytic fungi from comfrey (Symphytum officinale L.) for in vitro biological control of the phytopathogen Sclerotinia sclerotiorum (Lib.).
机构信息
Departamento de Biologia Estrutural, Molecular e Genética, Universidade Estadual de Ponta Grossa , Ponta Grossa, PR , Brasil.
出版信息
Braz J Microbiol. 2009 Jan;40(1):73-8. doi: 10.1590/S1517-838220090001000011. Epub 2009 Mar 1.
Biological control consists of using one organism to attack another that may cause economic damage to crops. Integrated Pest Management (IPM) is a very common strategy. The white mold produced by Sclerotinia sclerotiorum (Lib.) causes considerable damage to bean crops. This fungus is a soil inhabitant, the symptoms of which are characterized by water-soaked lesions covered by a white cottony fungal growth on the soil surface and/or the host plant. Possible biological control agents taken from plants are being investigated as phytopathogen inhibitors. These are endophytic microorganisms that inhabit the intercellular spaces of vegetal tissues and are often responsible for antimicrobial production. The objective of the present study was to select endophytic fungi isolated from comfrey (Symphytum officinale L.) leaves with in vitro antagonist potential against the phytopathogenic fungus S. sclerotiorum. Twelve isolates of endophytic fungi and a pathogenic strain of S. sclerotiorum were used in the challenge method. With the aid of this method, four endophytes with the best antagonistic activity against S. sclerotiorum were selected. Pathogen growth inhibition zones were considered indicative of antibiosis. The percentages of pathogenic mycelia growth were measured both with and without the antagonist, resulting in growth reductions of 46.7% to 50.0% for S. sclerotiorum. These analyses were performed by evaluating the endophytic/pathogenic mycelia growth in mm/day over an eight-day period of antagonistic tests.
生物防治包括利用一种生物来攻击另一种可能对作物造成经济损害的生物。综合虫害管理(IPM)是一种非常常见的策略。核盘菌(Sclerotinia sclerotiorum (Lib.))产生的白霉会对豆类作物造成相当大的损害。这种真菌是一种土壤寄居菌,其症状表现为土壤表面和/或宿主植物上覆盖着水渍状病斑,上面有白色棉絮状真菌生长。人们正在从植物中寻找可能的生物防治剂,作为植物病原菌抑制剂。这些是内生微生物,栖息在植物组织的细胞间隙中,通常负责产生抗微生物物质。本研究的目的是从紫草(Symphytum officinale L.)叶片中选择具有体外拮抗潜力的内生真菌,以对抗植物病原菌核盘菌。在挑战方法中使用了 12 株内生真菌和一株致病性核盘菌菌株。借助该方法,选择了 4 株对 S. sclerotiorum 具有最佳拮抗活性的内生真菌。抑菌活性通过抑制病原菌生长来评估,抑制病原菌生长的区域表明存在抗生性。在有无拮抗剂的情况下,均测量了病原菌菌丝的生长百分比,导致 S. sclerotiorum 的生长减少了 46.7%至 50.0%。这些分析是通过在拮抗试验的八天期间内评估内生/病原菌菌丝的 mm/天生长来进行的。